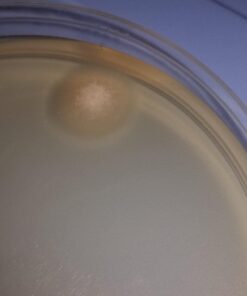
Backyard Morel Mushroom Growing Kit - MOREL HABITAT KIT ® 47 61IyOtZY4jL

Backyard Morel Mushroom Growing Kit – MOREL HABITAT KIT ®
Description
Features:
- Grow Morel Mushrooms in your yard. Start any time your soil is workable – Spring, Summer, Fall and even Winter (in areas with a mild climate).
- Create an earth friendly, sustainable, organic, outdoor Morel Mushroom garden & grow morels in your backyard.
- We provide Complete instructions and Guaranteed* to produce spawn (seed), of our unique morel mushroom strains which will allow you to grow pounds of morels.
- Morel Habitat Kit since 1989; customers have found morels in their Morel Habitats 25 years after they were established!
- Certified Organic by Quality Assurance International (QAI). Made in USA. Use morel spawn immediately or store for up to six months.
Product Details:
- Plant or Animal Product Type: Morel Mushroom
- Indoor/Outdoor Usage: Outdoor
- Brand: MOREL HABITAT KIT
- Material Feature: Organic
- Color: Golden Brown
- Special Feature: Morel Garden
- Expected Blooming Period: Spring
- Item Weight: 1.4 Pounds
- Sunlight Exposure: Partial Shade
- Unit Count: 1 Count
- Plant or Animal Product Type: Morel Mushroom
- Indoor/Outdoor Usage: Outdoor
- Brand: MOREL HABITAT KIT
- Material Feature: Organic
- Color: Golden Brown
- Special Feature: Morel Garden
- Expected Blooming Period: Spring
- Item Weight: 1.4 Pounds
- Sunlight Exposure: Partial Shade
- Unit Count: 1 Count
- Expected Planting Period: Any time you can turn your soil
- Product Care Instructions: Partially shaded and slightly moist.
- USDA Hardiness Zone: All Zones
- Expected Plant Height: 6 Inches
- Soil Type: Any soil you can turn with a shovel
- Moisture Needs: Little To No Watering
- Number of Pieces: 1
- Product Dimensions: 5.12 x 5.12 x 5.12 inches
- Item Weight: 1.4 pounds
- Manufacturer: Gourmet Mushrooms
- Country of Origin: USA
- Item model number: MHK
- Is Discontinued By Manufacturer: No

Caramel CC102A Zebra Wood Concert Acoustic Ukulele With Truss Rod
Etekcity Upgraded Remote Control Outlet Wireless Light Switch for Household Appliances, Plug and Go, Up to 100 ft. Range, FCC Certified, ETL Listed, White (Learning Code, 3Rx-1Tx)
6 Pack Bioluz LED"Flame Tip" Dimmable Candelabra LED E12 Candelabra Base Candle Bulbs 2700K (Warm White) 40 Watt Using only 5 Watts, Chandelier, Indoor/Outdoor Flame Tip - 6 Pack
BLACK+DECKER 20V MAX Lithium Battery Charger (LCS1620B)
CHICKEN LOVER Street Sign ~ Custom Sticker Decal Wall Window Door Art Vinyl Street Signs - 8.25" X 2.0"
Gerber EAB Lite Pocket Knife [31-000345]
OcarinaWind 12 Hole White Ocarina Exquisite Craft of Ice-crack Alto C Version Music Instrument Gift Idea
Set of 4 - Acoustic Foam Acoustic Studio Soundproofing Corner Wall 12" X 12" X 24" 4 PACK